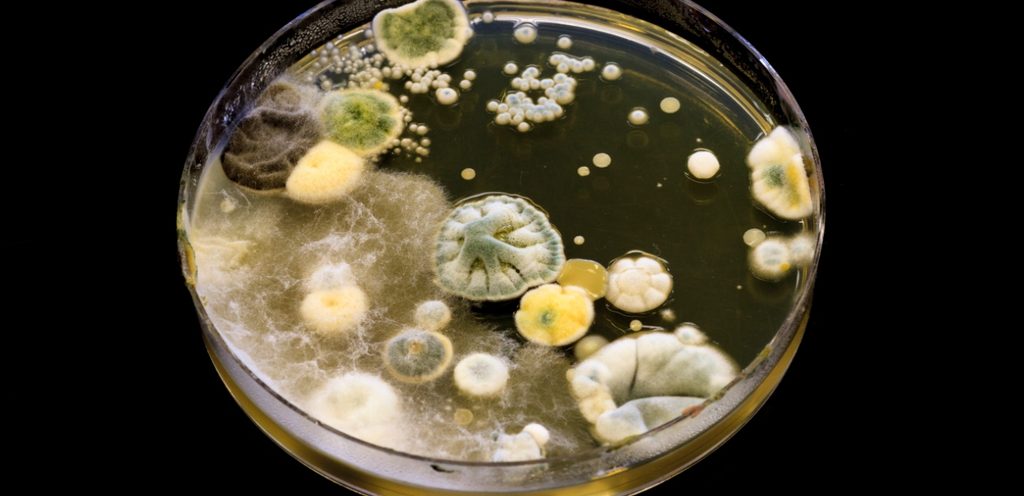

يمكن أن يؤدي تنفس الهواء الغني بالعفن إلى مخاطر صحية كبيرة، مع علامات وأعراض مختلفة تشير إلى سمية محتملة. اعراض العفنه عند الطفل تختلف من طفل لآخر ولكنها مشتركة بمعظمها.
إذا تعرضت أنت أو عائلتك لمستويات أعلى من العفن، فقد يعانون من مشاكل في الجهاز التنفسي مثل السعال وضيق التنفس والصفير. أيضًا، يمكن أن تكون ردود الفعل التحسسية مثل احتقان الأنف والعطس وتهيج الجلد بعض العلامات الأساسية التي يمكنك البحث عنها. ولكن قبل أن ندخل في ذلك، نحتاج إلى الإجابة على بعض الأسئلة الملحة حول سمية العفن. حساسية القمح عند الاطفال: طرق اكتشافها وأساليب العلاج الآمنة!
كيف نعرف أنّ العفن سام
تحديد ما إذا كان العفن سامًا أمر صعب للغاية. ولكنه ينطوي أيضًا على تقييم العلامات المرئية المختلفة مثل الروائح العفنة ومراقبة الأعراض الصحية مثل الصداع وتهيج الجلد وما إلى ذلك. واحدة من أكثر الطرق دقة هي عن طريق جدولة اختبار العفن الاحترافي. لن يقدم دليلًا على السمية فحسب، بل سيقدم أيضًا علاجًا سريعًا لأي نمو للعفن لمنع المخاطر الصحية.

اعراض العفنه عند الطفل
إذا كان أحد مخاوفك هذه الأيام هو أن منزلك قد يتعرض للعفن، لكنك ما زلت غير متأكدة. أو إذا لم تجديه بعد، فأنت بحاجة إلى إيلاء اهتمام خاص لصحتك وصحة أحبائك في منزلك. في ما يلي علامات تحذيرية لسمية العفن والتي تشير على الأرجح إلى وجود العفن في منزلك.
القضايا المعرفية
واحدة من أهم علامات التحذير من التعرض للعفن هي القضايا المعرفية؛ قد تشمل ضباب الدماغ وضعف الذاكرة والقلق. إذا كنت تتعاملين مع سمية العفن في منزلك مع أطفالكِ، فمن المحتمل جدًا أن يواجهون صعوبة في التركيز. في الواقع، قد يواجهون أيضًا مشكلات في تذكر أحداث معينة وتفاصيل وما إلى ذلك.
التعب
يمكن أن تكون سمية العفن أحد أسباب مشاكل مثل التعب والدوخة والإرهاق. بشكل عام، يمكننا أن ننسب إليها الفضل في ضعف الجسم. في الآونة الأخيرة، إذا لاحظت أيًا من هذه الأعراض بشكل متكرر على طفلكِ، فقد حان الوقت للتحقق من منزلك بحثًا عن العفن، وهناك فرصة كبيرة للعثور عليه. السبب وراء ذلك هو أن جراثيم العفن تتحرك عبر الرئتين والممرات الأنفية، مما يسبب هذه المشاكل في نهاية المطاف.
الصداع والصداع النصفي
العلامات الأخرى لسمية العفن هي الصداع والصداع النصفي. إذا كنت أنتِ أو أي من أطفالكِ تعانون من هذه المشكلات مرارًا وتكرارًا، فأنتم بحاجة إلى التحقق من سمية العفن. إلى جانب ذلك، من الأفضل أيضًا الذهاب لرؤية الطبيب على الفور.
مشاكل الجلد
يمكنك أن يواجه أطفالكِ مشاكل جلدية مختلفة عند التعرض لسمية العفن. سواء كانت حكة أو طفح جلدي أو خلايا، فهذه كلها علامات على أن مشكلة كبيرة تتربص في منزلك. بينما، بالإضافة إلى البحث عن العفن، يمكنك أيضًا استشارة طبيبك أو طبيب الأمراض الجلدية في أسرع وقت ممكن قبل تفاقم حالة بشرة طفلكِ. يمكنك أيضًا استخدام كريمات الهيدروكورتيزون التي يمكن أن تساعدك في مشاكل الجلد.

مشاكل في الجهاز التنفسي
إذا تعرض منزلك للعفن، فقد تلاحظين في طفلكِ الصفير المتكرر وضيق التنفس والسعال وما إلى ذلك. في الواقع، قد تحدث نوبة الربو أيضًا إذا كانوا يعانون من سمية العفن. في هذه الحالة، قد تحتاجين إلى التحقق من العفن، لأن مشاكل الجهاز التنفسي هي واحدة من علامات التحذير الرئيسية لسمية العفن وتعرضه. توقفي عن الإفراط في تقديم الأدوية: الحل الطبيعي لتعزيز مناعة طفلك يكمن هنا!
مشاكل في الجهاز الهضمي
إذا كان طفلكِ يعاني من سمية العفن، فقد يواجه أيضًا مشاكل في الجهاز الهضمي مثل:
- غثيان
- قيء
- ألم في البطن
- إسهال
- نزيف معوي
قد يعانون من سمية العفن في الطعام، وبشكل أكثر تحديدًا. لهذا السبب من الأفضل التحقق من العفن في المناطق التي تخزن فيها الطعام والتوابل. التحقق من العفن مهم حقا لتجنب استنشاق أو تناول المنتجات الغذائية مع تلوث العفن. ناهيك عن أن هذه التغييرات قد تسبب أيضًا تغيرات في الشهية والوزن.
آلام المفاصل وآلام العضلات
آلام المفاصل والتصلب والآلام هي أيضًا علامات على سمية العفن. في الواقع، يمكن أن يؤدي أيضًا إلى الالتهابات والتهاب المفاصل الفطري. من المهم أيضًا أن تظلي يقظة.
الحساسية في الحواس
يؤدي التعرض للعفن أيضًا إلى حساسية في الحواس، مثل الصوت والبصر. قد يواجه طفلك أيضًا زيادة في الحساسية للضوضاء والتعرض للضوء؛ كلاهما يعمل كأعراض. هذه تسبب عدم الراحة ويمكن أن تؤدي أيضًا إلى مشاكل مختلفة مثل الأرق وتغيرات المزاج.
برأيي الشّخصي، يمكن أن يؤدي التعرض للعفن على المدى الطويل إلى عواقب صحية خطيرة لن تسبب الحساسية ولكنها ستؤدي أيضًا إلى مشاكل صحية رئيسية أخرى. في الواقع، يمكن أن يؤدي التعرض المطول للعفن أيضًا إلى حدوث حالات مثل الربو وقد يؤدي أيضًا إلى مشاكل تنفسية مزمنة. لذلك، لا تترددي في استشارة طبيب طفلكِ بهدف جمايته حالما تظهر بعض الأعراض.

























